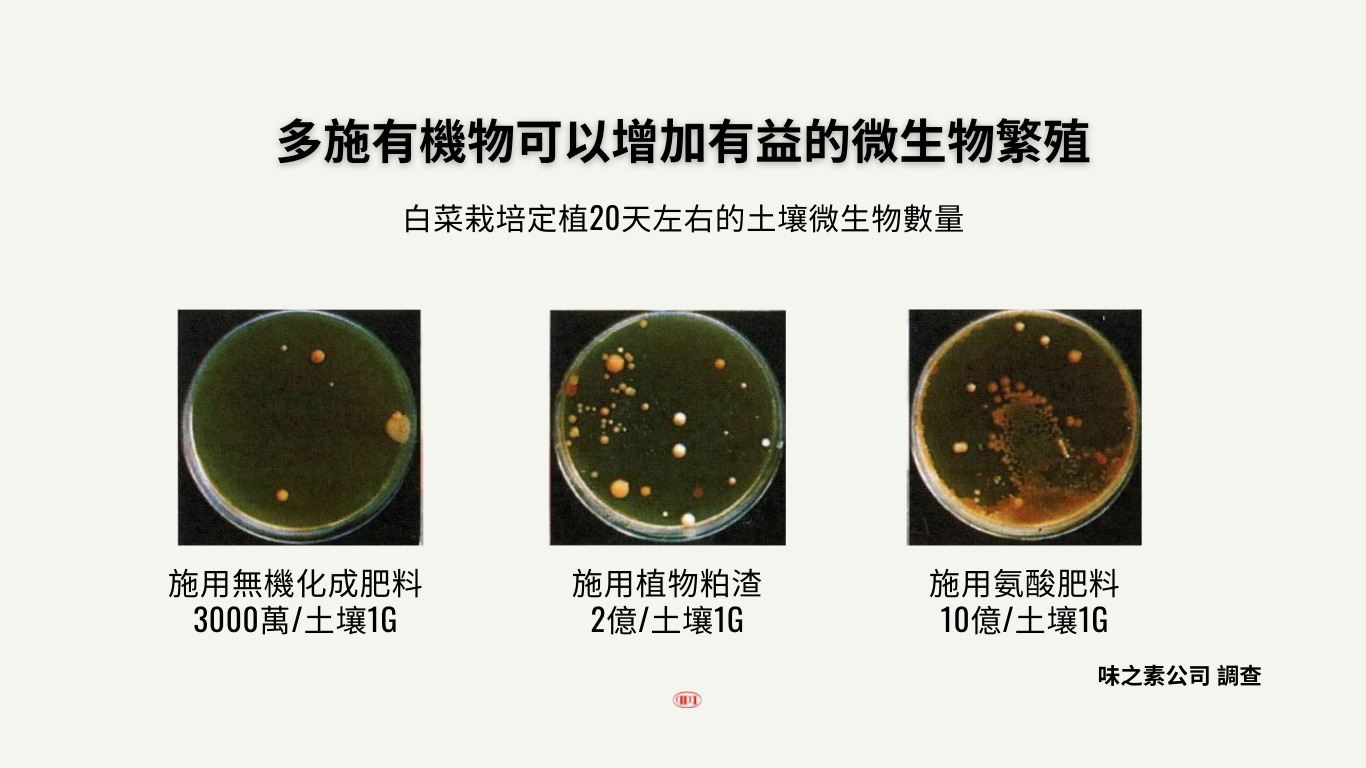

鮮艷
商品名: 鮮艷
商品規格:500g、1KG、5KG、20KG
商品成份:全氮(2.5%)、水溶性氧化鎂(13%)、水溶性硼(0.3%)、水溶性錳(5.5%)、全鋅(0.07%)、水溶性(0.04%)、水溶性鐵(0.42%)、全銅(0.04%)
原料:胺基酸(甘胺酸、丙胺酸)、硫酸鎂、硫酸錳、硼酸、EDTA-鐵、硫酸銅、硫酸鋅、鉬酸鈉。
肥料登記字號:進微0053089
特點:
日本製
微量元素一次補充到位
綜合補帖
歡迎透過line詢問,點我加好友,也可以掃描以下QR code

商品名: 鮮艷
商品規格:500g、1KG、5KG、20KG
商品成份:全氮(2.5%)、水溶性氧化鎂(13%)、水溶性硼(0.3%)、水溶性錳(5.5%)、全鋅(0.07%)、水溶性(0.04%)、水溶性鐵(0.42%)、全銅(0.04%)
原料:胺基酸(甘胺酸、丙胺酸)、硫酸鎂、硫酸錳、硼酸、EDTA-鐵、硫酸銅、硫酸鋅、鉬酸鈉。
肥料登記字號:進微0053089
特點:
日本製
微量元素一次補充到位
綜合補帖

此商品暫無評價
為了讓您有更好的網站使用體驗,我們會使用一些稱為「Cookie」的小檔案來記住您的偏好設定、分析網站使用情況,並提供適合您的內容。您可以選擇要使用哪些功能。
確保網站基本功能正常運作,例如:登入狀態、購物車內容、安全防護等。
了解訪客如何使用網站,例如:最受歡迎的頁面、停留時間、點擊行為等。
根據您的瀏覽習慣顯示相關的廣告和產品推薦。
記住您的個人偏好,例如:語言選擇、字體大小、主題顏色等。
